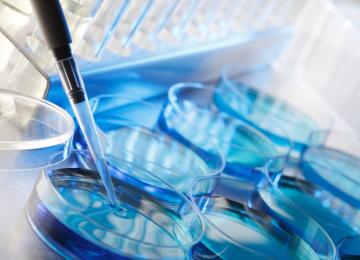

Meteorologists say a cold front entering Iran from the west will instigate rainfall in western and northwest parts of the country, whereas Khuzestan Province might have to deal with dust storms.…
People
<p>Iran people news, Read the latest news on Iran's society, including developments in sciences, education, universities, and students, along with stories about Iran health sector. </p>
- People
The United Nations Food and Agriculture Organization “feels responsible” for protecting Zagros forests, according to a FAO official in Iran.
“We have plans to develop sustainable…
PeoplePeople who smoke cigarettes may boost their risk of clogged heart arteries by weakening a gene that is otherwise protective of these important blood vessels, US researchers said on Monday.
…
PeopleA new study by Tehran University of Medical Sciences (TUMS) has prepared a list of 10 leading causes of death in Tehran and two of its major counties.
PeopleIn spite of remarkable progress in medical fields, Iran is lagging in the prevention and treatment of brain strokes, said to be the second leading cause of mortality in the country.
PeopleThe results of evaluation of the 48 medical universities across the country based on 42 indices for the purpose of re-accreditation showed that only six universities are fully compliant with the…
PeopleFifteen new infertility treatment centers have been inaugurated in several provinces across the country. Health Minister Hassan Qazizadeh Hashemi attended the inauguration ceremonies…
PeopleDuring the Teacher’s Week (May 1-7), students of the Me’raj High School for girls, in District 5 of Tehran Municipality, praised their teachers’ selfless devotion to the student community.
PeopleA report released by Iran’s Legal Medicine Organization (ILMO) on Monday, said that last year (ended March 20), 547,021 individuals were injured in street fights of whom, 68% were men and 22% were…
PeopleUnder a memorandum of understanding between the Belgian Ghent University and Shiraz University of Iran, the two universities will grant joint PhD degrees in a number of fields including veterinary…
PeopleAn Aeroflot Boeing 777 flying from Moscow to Bangkok on Monday hit air pockets around 40 minutes before landing at Suvarnabhumi Airport, leaving more than two dozen injured.
An Aeroflot…
PeopleThe US State Department urged citizens going to Europe this summer to be extra vigilant, issuing a travel alert to the continued threat of terrorist attacks.
The alert, issued on Monday,…
PeopleTwo German tourists died and at least 17 were injured when a minibus crashed in Fars Province, local media reported.
The minibus, which was carrying 16 German tourists, overturned while…
PeopleMore than 80 relics—some older than 2,000 years—have been seized in Sari, Mazandaran Province, the provincial police chief said.
PeopleIran has signed a memorandum of understanding with a Spanish hotel firm to restore historical structures in Iran and repurpose them into lodging facilities.
PeopleIran's row with Saudi Arabia blocked half of its inbound tourists from the Middle East, according to a Tehran city councilor.
PeopleDuring the past four years, 33,760 small-scale rural development programs were completed across the country, said Saeed Reza Jandaqian, deputy of rural affairs at the Municipal and Rural…
PeopleWhile colic is common among infants, a new study suggests that a mother’s relationship happiness and level of social support might play a role in the condition.
PeopleUnemployment after hospitalization is associated with a 50% higher risk of death in patients with heart failure, according to research presented at Heart Failure 2017 and the 4th World Congress on…
PeopleThe rate of youth participation in various political, social and economic areas though non-governmental organizations has increased by 40% over the past four years.
PeopleTwo new vaccines have been added to the national childhood immunization program as planned in the World Immunization Week (April 24-30), announced director of the Health Ministry’s Preventable…
PeopleThe likelihood of inflammable material thrown in the open storm water drains on Police Street, Shariati Avenue in Tehran was the cause of an outbreak of fires that saw cars parked alongside burst…
PeopleWith presidential elections just around the corner (May 19), the incumbent administration’s first term in office is under scrutiny in several areas, including healthcare – key indicators of a…
PeopleThe growing trend of divorce in the past decade has raised some serious concern among the authorities, forcing them to step in and take measures to check and reverse the high rate of marriage…
PeopleImproving the energy efficiency of key sectors and reducing air pollution are high on the agenda of the Ministry of Roads and Urban Development, a deputy at the ministry said.
Pirouz…
People